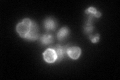
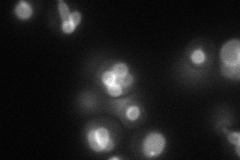
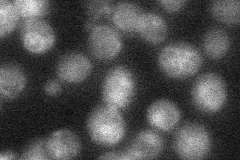
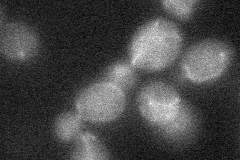

View description
Protein of unknown function, localized to the vacuolar outer membrane; predicted to be palmitoylated
Localization:
Intensity:
Fold change:
Significance:
-
C’ GFP library in SD
vacuole membrane92.64 -
N' NOP1pr-GFP in SD
vacuole membrane66.8262 -
N' TEF2pr-mCherry in SD

vacuole membrane104.058 -
N' NATIVEpr-GFP in SD
vacuole membrane19.1741 -
N' TEF2pr-VC and Cyto-VN in SD
below threshold26.6898 -
C’ GFP library in SD+DTT

vacuole membrane75.830.81No -
C’ GFP library in SD+H2O2

vacuole membrane53.30.57Yes -
C’ GFP library in Starvation Media

vacuole membrane110.581.19No -
C’ GFP library on the background of Pup2-DaMP

vacuole membrane -
C’ GFP library on the background of CCT mutant

vacuole membrane67.68720.730619No
